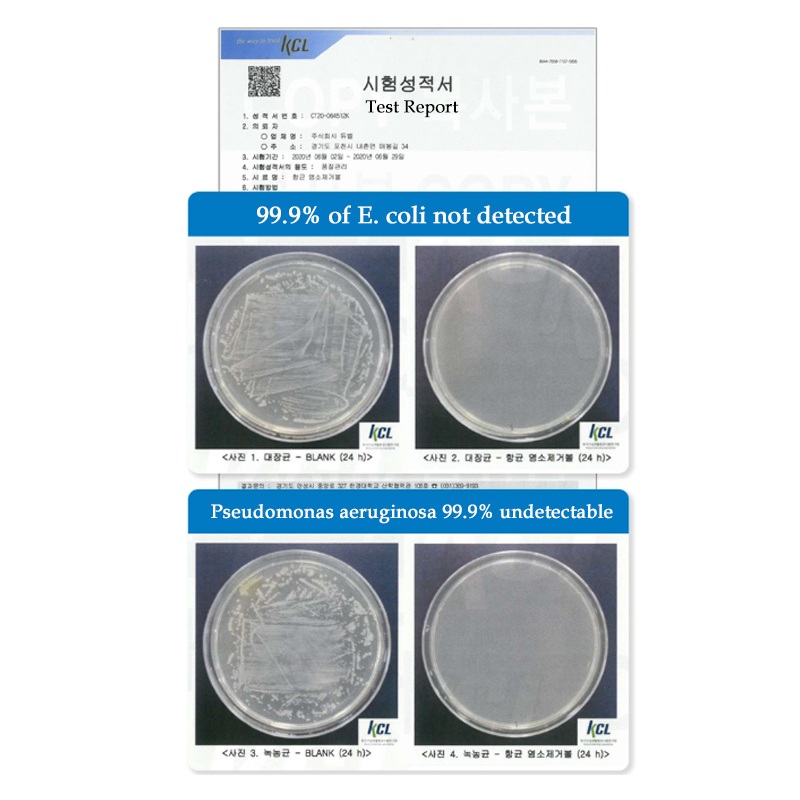

1/12
3 Variações Disponíveis
no Pix >
★ Llucete SLOWN Kit De Filtro De Torneira De Lavatório 3 Em 1 Remoção De Cloro Residual E odor De Substâncias Estrangeir
Frete grátis R$13,00 R$0,00 com cupom
Produto internacional objeto de declaração de importação e sujeito a impostos estaduais e federais